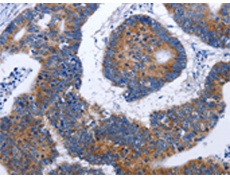
一抗

|
Background: |
This gene encodes a subunit of the elongation factor-1 complex, which is responsible for the enzymatic delivery of aminoacyl tRNAs to the ribosome. This subunit contains an N-terminal glutathione transferase domain, which may be involved in regulating the assembly of multisubunit complexes containing this elongation factor and aminoacyl-tRNA synthetases. Probably plays a role in anchoring the complex to other cellular components. |
|
Applications: |
ELISA, WB, IHC |
|
Name of antibody: |
EEF1G |
|
Immunogen: |
Fusion protein of human EEF1G |
|
Full name: |
eukaryotic translation elongation factor 1 gamma |
|
Synonyms: |
EF1G, GIG35 |
|
SwissProt: |
P26641 |
|
ELISA Recommended dilution: |
1000-5000 |
|
IHC positive control: |
Human colon cancer |
|
IHC Recommend dilution: |
50-200 |
|
WB Predicted band size: |
50 kDa |
|
WB Positive control: |
Human liver cancer tissue |
|
WB Recommended dilution: |
500-2000 |


 購物車
購物車 幫助
幫助
 021-54845833/15800441009
021-54845833/15800441009